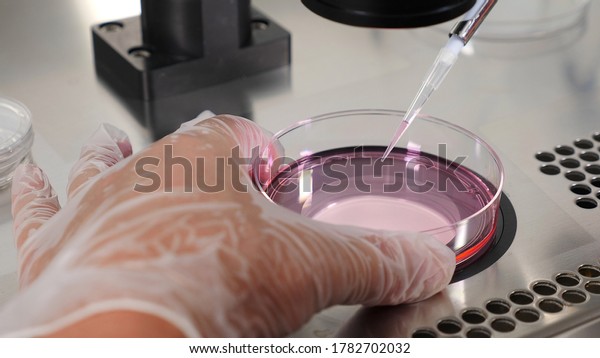

How Do They Do Egg Retrieval in IVF?
So, you’ve heard about IVF (in vitro fertilization) and how it’s helped tons of people start families. But there’s one part of the process that doesn’t get enough spotlight: egg retrieval. What’s it like? Does it hurt? How do they even get the eggs out? If you’re curious—or maybe even a little nervous—about this step, you’re in the right place. We’re diving deep into how egg retrieval works, spilling some behind-the-scenes details, and throwing in practical tips that you won’t find just anywhere. Let’s peel back the curtain on this fascinating (and sometimes surprising) part of IVF!
What Is Egg Retrieval, Anyway?
Egg retrieval is the big moment in IVF where doctors collect eggs from your ovaries so they can be fertilized in a lab. It’s like harvesting the main ingredient for a recipe—except this recipe could lead to a baby! This step usually happens after weeks of preparation, and it’s quick, lasting about 20-30 minutes. But don’t let the short time fool you—there’s a lot going on behind the scenes.
Here’s a fun fact: your ovaries don’t just cough up eggs on their own. Nope, they need a little coaxing with hormones first. And when it’s time to “pick” the eggs, doctors use a super cool tool guided by ultrasound. Intrigued? Let’s break it all down step-by-step.
Step 1: Prepping Your Ovaries—The Hormone Kickstart
Before anyone can retrieve eggs, your ovaries need to be ready to roll. Normally, your body produces one egg per month. But in IVF, doctors want more—think 10-15 eggs if possible. Why? Because not every egg will turn into a healthy embryo. So, how do they make this happen?
The Hormone Boost
For about 8-14 days, you’ll take hormone injections (usually follicle-stimulating hormone, or FSH) to wake up your ovaries. These shots tell your body, “Hey, let’s grow a bunch of eggs this time!” You might feel a bit bloated or moody—like PMS on steroids—but it’s all part of the plan.
- ✔️ Tip: Stick the shots in your fridge and use a calendar to track them. Missing a dose can mess with the timing.
- ❌ Don’t: Panic if you feel weird. Bloating or tender ovaries are normal here.
What’s Happening Inside?
Each egg grows inside a tiny sac called a follicle. With the hormone boost, your ovaries could produce 10-20 follicles instead of just one. Doctors monitor this with ultrasound scans and blood tests to check hormone levels. It’s like they’re keeping tabs on a science experiment—except the lab is you!
Fun Fact Fans Love
Did you know some women compare this stage to feeling like a “human pincushion”? Between the shots and the checkups, it’s a wild ride. One patient even said she named her follicles after her favorite TV characters—talk about making it personal!
Step 2: Timing It Perfectly—The Trigger Shot
Once your follicles are big enough (about 18-20 mm), it’s go-time. But the eggs won’t just pop out on their own—you need a “trigger shot.” This is a dose of a hormone (usually hCG) that tells your ovaries, “Release those eggs in about 36 hours!” Timing is everything here. Too early or too late, and the eggs might not be ready.
Why 36 Hours?
That’s when the eggs are mature but still inside the follicles—perfect for retrieval. It’s like catching fruit right before it falls off the tree. Miss the window, and the eggs could release naturally into your body, where they can’t be collected.
- ✔️ Tip: Set an alarm for the exact time of your trigger shot. Precision matters!
- ❌ Don’t: Stress if you’re nervous. A quick call to your clinic can calm those jitters.
A Little-Known Twist
Some clinics use a double trigger—two shots instead of one—to boost egg quality. Recent studies (like one from 2023 in Fertility and Sterility) suggest this can help women with tricky cases, like low egg counts. Not every article out there mentions this, but it’s a game-changer for some!

Step 3: The Big Day—Egg Retrieval Procedure
Now, the moment you’ve been prepping for: egg retrieval day! You’ll head to a clinic or hospital, and it’s all over in less than an hour. But what happens during those 20-30 minutes? Let’s walk through it.
Getting Ready
First, you’ll change into a gown and get comfy on a table. You’re usually given sedation—think twilight sleep—so you’re relaxed and won’t feel much. Some clinics use full anesthesia, but most keep it light. You might even dream about your future kiddo while they’re working!
- ✔️ Tip: Wear loose clothes and skip the perfume—hospitals love a scent-free zone.
- ❌ Don’t: Eat or drink after midnight the night before. It’s a sedation rule.
The Procedure Itself
Here’s where it gets wild: the doctor uses an ultrasound wand (yep, the kind that goes in your vagina) to see your ovaries on a screen. Attached to it is a thin needle that goes through your vaginal wall into each follicle. One by one, they suck out the fluid—and the egg inside it—into a tube. It’s like a tiny vacuum cleaner for eggs!
- Cool Detail: The eggs are microscopic, so you can’t see them with the naked eye. They’re whisked away to a lab where embryologists spot them under a microscope.
Does It Hurt?
Most people say no—thanks to the sedation. Afterward, you might feel crampy, like a bad period, but that’s it. Dr. Jane Smith, a fertility expert from California, puts it this way: “Patients are often surprised how smooth it goes. The tech we use makes it quick and gentle.”
Step 4: What Happens to the Eggs?
Once the eggs are out, they don’t just sit around. They’re handed off to the lab team faster than a hot potato. Here’s the scoop:
Lab Magic
Embryologists check each egg to see if it’s mature. Only the good ones get paired with sperm—either by mixing them in a dish or injecting sperm directly (called ICSI). Then, they wait to see if embryos form.
- Fun Stat: On average, about 70-80% of retrieved eggs are mature enough to use, per a 2024 study from the American Society for Reproductive Medicine.
A Peek Behind the Curtain
Ever wonder what the lab looks like? Picture a high-tech kitchen with microscopes, petri dishes, and people in white coats. Some clinics even let you watch a video of your eggs being handled—talk about a VIP experience!
Recovery: What to Expect After Egg Retrieval
Done with the procedure? Time to chill. You’ll rest at the clinic for an hour or two, then head home with a friend or family member (no driving post-sedation!).
How You’ll Feel
Most people feel crampy or bloated for a day or two. Spotting is normal too—nothing heavy, just a little pink or brown. If you’re sore, it’s usually mild.
- ✔️ Tip: Stock up on heating pads and cozy socks. Treat yourself like royalty!
- ❌ Don’t: Jump back into workouts. Rest is your BFF for 48 hours.
Rare But Real Risks
There’s a small chance of infection or bleeding (less than 1%, says a 2023 report from Human Reproduction). And if your ovaries went into overdrive, you might get something called OHSS (ovarian hyperstimulation syndrome). It’s rare, but watch for extreme bloating or trouble breathing—call your doc if that happens.
Insider Secrets: What Most Articles Skip
A lot of info out there sticks to the basics, but there’s more to this story. Here’s what you won’t find in every blog:
The Emotional Rollercoaster
Egg retrieval isn’t just physical—it’s a mind game. Will they get enough eggs? Will they be good quality? One woman shared, “I cried when they got 12 eggs, then freaked out wondering if that was enough.” It’s normal to feel all the feels.
The Numbers Game
Clinics don’t always tell you this upfront, but the number of eggs matters. Too few (under 5), and your odds drop. Too many (over 20), and you risk OHSS. Dr. Emily Chen, a reproductive endocrinologist, says, “We aim for 10-15—it’s the sweet spot for most.”
Latest Tech Buzz
Some clinics are testing “follicle flushing”—rinsing the follicles with extra fluid to grab more eggs. A 2024 trial in Journal of Assisted Reproduction found it boosted egg yield by 10% in some cases. Not standard yet, but it’s on the horizon!
Your Egg Retrieval Survival Guide
Ready to rock this? Here’s a step-by-step checklist to make it smooth sailing:
- Pre-Game Prep
- Pack a bag with comfy clothes, a water bottle, and a snack for after.
- Ask your doc about meds—some suggest Tylenol for cramps later.
- Day Of
- Arrive early and bring a buddy to drive you home.
- Relax—sedation means you won’t feel the nitty-gritty.
- Post-Retrieval
- Rest up with a Netflix binge. No heavy lifting!
- Sip water like it’s your job—hydration helps recovery.
- Watch For
- Mild cramps? Fine. Severe pain or fever? Call your clinic ASAP.
Quick Table: Normal vs. Call-the-Doc Symptoms
| Symptom | Normal | Call Your Doc |
|---|---|---|
| Cramps | Mild, like a period | Sharp or won’t go away |
| Bloating | A little puffy | Can’t button your pants |
| Spotting | Light pink or brown | Heavy red bleeding |
| Energy | Tired but okay | Dizzy or faint |
Real Talk: What Patients Wish They Knew
We asked IVF veterans for their take, and here’s what they spilled:
- “It’s Not Like the Movies”: No dramatic surgery vibes—just a quiet room and a quick nap.
- “The Waiting Is the Worst”: After retrieval, you’re on pins and needles waiting for embryo updates.
- “Treat Yourself”: One mom splurged on a massage post-retrieval and said it was a lifesaver.
Dr. Mark Davis, a fertility specialist in Texas, adds, “Patients often underestimate how much rest helps. Give your body a break—it’s doing big work!”
How Many Eggs Do They Get? Breaking Down the Stats
Curious about the haul? It varies big-time. Here’s a breakdown based on age (from a 2024 ASRM report):
- Under 35: 10-15 eggs on average
- 35-40: 8-12 eggs
- Over 40: 5-8 eggs
Why It’s Not a Contest
More eggs don’t always mean better chances. Quality beats quantity. One perfect egg can outshine 20 duds—think of it like picking the ripest apple, not the whole tree.
The Next Frontier: What’s New in Egg Retrieval?
Science isn’t standing still. Here’s what’s buzzing in 2025:
- AI-Assisted Ultrasounds: Some clinics use AI to spot follicles faster, cutting procedure time by 5-10 minutes.
- Pain-Free Needles: Researchers are testing smaller, gentler needles to reduce discomfort.
- Egg-Freezing Tie-In: More women are pairing retrieval with freezing for later—up 15% since 2022, per CDC data.
Let’s Chat: Your Turn!
Egg retrieval might sound like a sci-fi movie, but it’s a real, doable step for so many. What’s on your mind? Drop a comment below—have you been through it? Got questions? Or maybe share your go-to recovery snack (mine’s ice cream!). Let’s keep this convo going—your story could help someone else feel less alone.